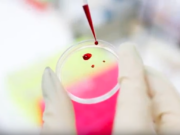
Fase 2 e Coronavirus: i test sierologici ci salveranno? fase-2-coronavirus-test-sierologici-ci-salveranno

Tags Fase 2
Tag: fase 2
Piacenza 100 giorni dopo: guardiamo avanti, ma niente colpi di spugna
Piacenza dopo 100 giorni di Covid. Negli occhi della gente che spuntano sopra le mascherine c'è tanta voglia di ricominciare. Di lasciarsi alle spalle...
Zandonella (Lega): dalla sicurezza ai giovani, nuove idee per la fase 2
Luca Zandonella: parla l'assessore alla Sicurezza e Giovani di Piacenza, e segretario cittadino della Lega. In questa doppia veste ha rilasciato un'intervista esclusiva a...
Lucia Fontana all’attacco: dure critiche all’Ausl di Piacenza e no al piano sulla fase...
Lucia Fontana all'attacco dell'Ausl di Piacenza. Dopo l'annuncio da parte dell'Azienda sanitaria della chiusura dei Pronto Soccorso di Castel San Giovanni e di Fiorenzuola...
Altro che fase 2, la Giustizia ha gettato la spugna
Per la Giustizia niente fase 2. Tutti pronti per ripartire? Certo, dal 18 maggio riapriranno tra mille polemiche bar e ristoranti, parrucchieri ed estetiste, tatuatori...
Fase 2: dal diario per i contatti a tutto ciò che si può fare...
Fase 2: domani si parte. Ma non tutti hanno chiaro quello che si può o non si può fare. Per questo il Governo, dopo...
Conte a Piacenza con Bonaccini e De Micheli: ecco cosa hanno detto su Covid-19...
Conte a Piacenza. Accompagnato dal ministro dei Trasporti e delle Infrastrutture Paola De Micheli, il premier ha avuto una serie di colloqui in prefettura...
Decreto caos sulla fase 2: dalla giustizia ai bambini, la confusione al potere
Decreto caos sulla fase 2: aspettavamo al varco il governo Conte e le sue corpose task force e così è stato. Con una conferenza...
Fase 2, la conferenza stampa di Conte
Fase 2, ecco che cosa ha detto il Presidente del Consiglio Giuseppe Conte da Palazzo Chigi sulla riapertura di attività produttive e della vita...
Fase 2, 3 o 4… ma senza scuola e materne aperte, il Pil resterà...
Fase 2: ripartiamo. Riapriamo tutto. Si deve tornare a lavorare. Bisogna impedire il disastro dei conti dietro l’angolo. Niente ferie, niente vacanze. La Lombardia...
Fase 2 e Coronavirus: i test sierologici ci salveranno?
Fase 2 e Coronavirus: forse siamo vicini alla fine dell’incubo. Tutti ci ricordano che bisognerà vivere distanziati, che dovremo per forza usare le mascherine...